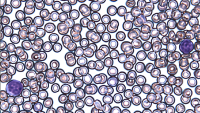
Cancer cells are significantly reduced after ATRA treatment which blocks a faulty β-catenin signal in the bone marrow that helps leukemia grow.

Azra Raza, MD
On the web

Overview
Dr. Raza is a Professor of Medicine and Director of the MDS Center at Columbia University in New York, NY. She started her research in Myelodysplastic Syndromes (MDS) in 1982 and moved to Rush University, Chicago, Illinois in 1992, where she was the Charles Arthur Weaver Professor in Oncology and Director, Division of Myeloid Diseases. The MDS Program, along with a Tissue Repository containing more than 50,000 samples from MDS and acute leukemia patients was successfully relocated to the University of Massachusetts in 2004 and to Columbia University in 2010.
Before moving to New York, Dr. Raza was the Chief of Hematology Oncology and the Gladys Smith Martin Professor of Oncology at the University of Massachusetts in Worcester. She has published the results of her laboratory research and clinical trials in prestigious, peer-reviewed journals such as The New England Journal of Medicine, Nature, Blood, Cancer, Cancer Research, the British Journal of Hematology, Leukemia, and Leukemia Research. Dr. Raza serves on numerous national and international panels as a reviewer, consultant, and advisor and is the recipient of a number of awards.
Areas of Expertise / Conditions Treated
- Acute Myelogenous Leukemia
- Acute Myelogenous Leukemia/AML
- Aplastic Anemia
- Myelodysplastic Syndrome
- Myelofibrosis
- Myeloproliferative Disease
Academic Appointments
- Chan Soon-Shiong Professor of Medicine at CUMC
Administrative Titles
- Director, Myelodysplastic Syndrome Center
Hospital Affiliations
- NewYork-Presbyterian / Columbia University Irving Medical Center
Gender
- Female
Schedule an Appointment
Phone Appointments
Connect Patient Portal
For existing patients, login to make an appointment, view documentation or contact your care provider.
Location(s)
Insurance Accepted
Aetna
- Aetna Signature Administrators
- EPO
- HMO
- Medicare Managed Care
- NY Signature
- POS
- PPO
- Student Health
Affinity Health Plan
- Essential Plan
- Medicaid Managed Care
Amida Care
- Special Needs
Cigna
- EPO
- Great West (National)
- HMO
- Medicare Managed Care
- POS
- PPO
Emblem/GHI
- Medicare Managed Care
- PPO
Emblem/HIP
- ConnectiCare
- EPO
- Essential Plan
- HMO
- Medicaid Managed Care
- Medicare Managed Care
- POS
- PPO
- Select Care (Exchange)
- Vytra
Empire Blue Cross/Blue Shield
- EPO
- HMO
- Medicare Managed Care
- PPO
Empire Blue Cross Blue Shield HealthPlus
- Child/Family Health Plus
- Essential Plan
- Medicaid Managed Care
Fidelis Care
- Child/Family Health Plus
- Essential Plan
- Medicaid Managed Care
- Medicare Managed Care
Healthfirst
- Child/Family Health Plus
- Leaf (Exchange)
- Medicaid Managed Care
- Medicare Managed Care
Healthspring (Cigna Medicare)
- Medicare Managed Care
Local 1199
- Local 1199
MagnaCare (National)
- MagnaCare
Medicare
- Railroad
- Traditional Medicare
Multiplan
- Multiplan
MVP Health Care
- Child/Family Health Plus
- Essential Plan
- HMO
- Medicaid Managed Care
RiverSpring
- Special Needs
UnitedHealthcare
- Compass (Exchange)
- Empire Plan
- HMO
- Medicaid (Community Plan)
- Medicare Managed Care
- Oxford Freedom
- Oxford HMO
- Oxford Liberty
- POS
- PPO
VNSNY CHOICE
- Medicare Managed Care
- SelectHealth
- Special Needs
WellCare
- Medicaid Managed Care
- Medicare Managed Care
World Trade Center Health Plan
- World Trade Center Health Plan
Credentials & Experience
Education & Training
- University of Maryland Medical Center
- Internship: 1979 Franklin Square Hospital
- Residency: Georgetown University Hospital
- Fellowship: Roswell Park Memorial Hospital
Board Certifications
- Internal Medicine
- Medical Oncology
Honors & Awards
Some of Dr. Raza's awards include The First Lifetime Achievement Award from APPNA, Award in Academic Excellence twice (2007 and 2010) from Dogana, Woman of the Year Award from Safeer e Pakistan, CA, and The Hope Award in Cancer Research 2012. Dr. Raza has been names as one of the 100 Women Who Matter by Newsweek Pakistan in March 2012.
Research
Dr. Raza belongs to that rare group of unique investigators who are adept at both basic and clinical research. Her basic research has been strictly therapy-driven and is marked by Dr. Raza's tireless efforts to move the advances in the laboratory to the bedside with alacrity for the improvement of treatment outcome of Myelodysplastic Syndrome (MDS) patients. Dr. Raza is well known internationally for several landmark observations related to the biology and treatment of MDS. She has published the results of her laboratory research and a large number of clinical trials in prestigious, peer reviewed journals such as The New England Journal of Medicine, Nature, Blood, Cancer, Cancer Research, British Journal of Hematology, Leukemia, Leukemia Research (250 full-length papers, 15 book chapters, 510 abstracts, and editor of a book devoted to MDS).
At Columbia University, Dr. Raza is the Director of the MDS Center which is backed by a basic research laboratory. There are a number of cutting edge clinical trials open for all stages of MDS patients at this Center. Dr. Raza serves on numerous National and International panels as a reviewer, consultant and advisor.